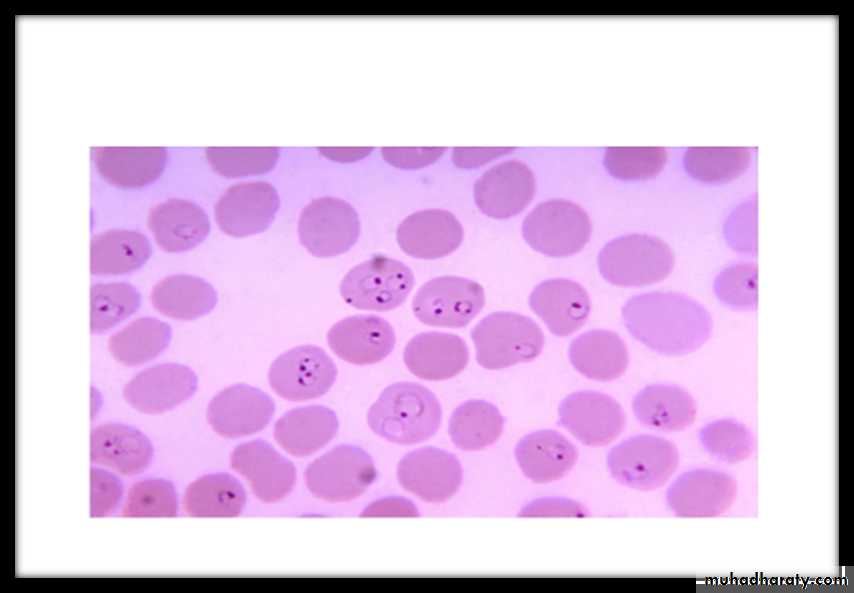
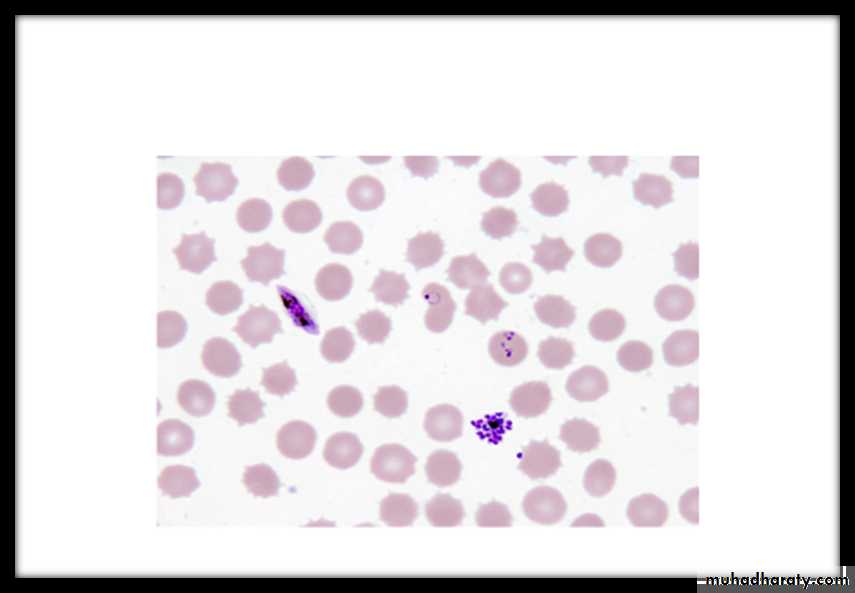
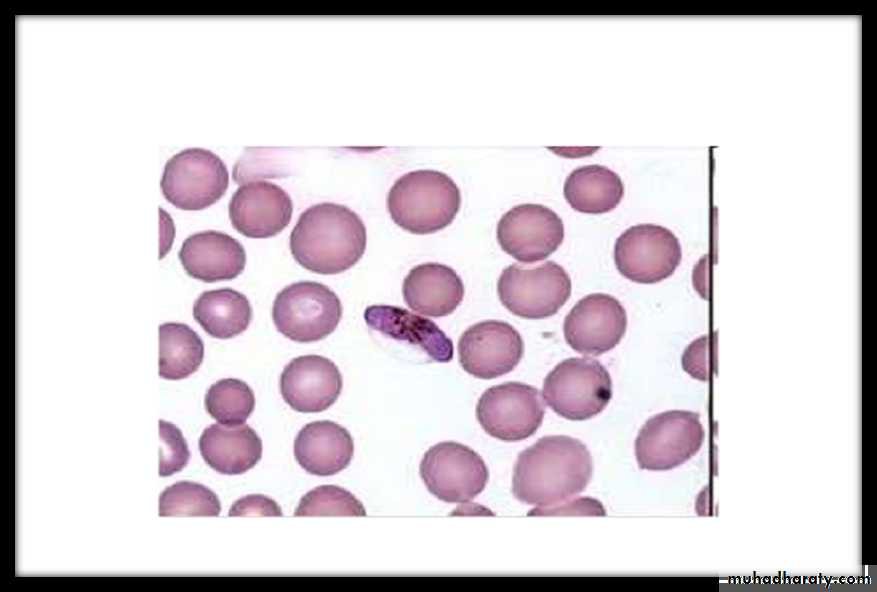
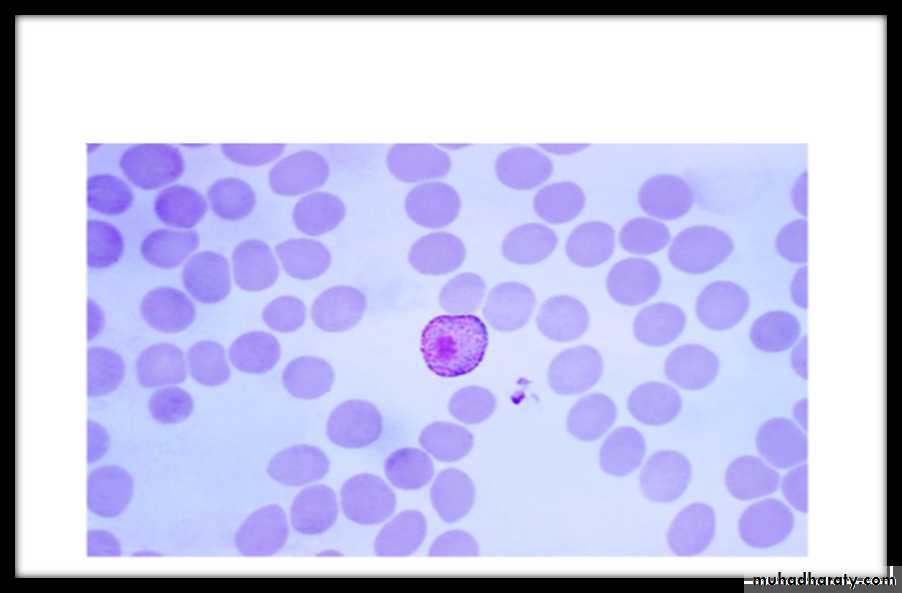

Class: sporozoa
Genus: plasmodiumIntroduction
• Malaria is a tropic life threatening disease.• Humans are infected with Plasmodium protozoa when bitten by an infective female Anopheles mosquito vector.
• Symptoms may appear within weeks to months or even years.
Classification
There are 4 species:plasmodium falciparum
plasmodium vivax
plasmodium ovale
plasmodium malariae
There are 4 species of plasmodium responsible for human malaria
P.vivax-benign tertian malaria. 48hrP.malariae-quartan malaria. 72hr
P.falciparum-malignant tertian or sub tertian malaria. 48hr
P. ovale-tertian or benign tertian malaria. 48hr
erythrocytic schizogony
• 48 hr in Pf, Pv, Po
• 72 hr in Pm
Morphology
The earliest form after the invasion of the R.B.C by the malarial parasite. is the trophozoite stage.The early trophozoite form rings usually with a single nucleus .As the troph.grows It will metabolize the haemoglobin of the R.B.C. and produce a darkly staining malarial pigment-hemozoin.
The nucleus of the trophozoite divides and it is now called immature schizont then each nuclear division surrounded by piece of cytoplasm forming mature schizont. Merozoits form& ruptures RBCs, then it infect other RBCs.
Some merozoites develops into gametocytes or sexual stage which have compact cytoplasm and no nuclear division.
P. vivax
The infected R.B.C. is enlarged because the parasite invade the reticulocytes –immature R.B.C. which is larger than other R.B.C. as the trophozoite grows, it form ring stage then the cytoplasm become irregular in shape with amoeboid extention forming amaeboid stage .Fine pink or reddish granules appear all over the infected R.B.C. these are schuffners dotes-believe to be an allergic reaction from the host to the presence of the parasite.• Malarial pigment in the cytoplasm of the parasite is fine light brown in colour
• In immature schizointes nucleus start division then.• The schizont matures in about 48 hrs. after the invasion of the R.B.C. and becomes segmented into 12- 16 merozoites .Gametocytes are round and nearly filling the R.B.C. all these stages are seen in the peripheral blood.
P. malariae
The infected R.B.C. is not enlarged because the parasite invade the old or mature R.B.C. ring are smaller than those of vivax and more compact, no schuffners dotes malarial pigments are coarse dark brown or black, trophozoite assume band shape across the infected R.B.C. mature schizont need 72 hrs.to develops contain 6-10 merozoits mostly 8 in No. which may be arranged in a rosette form with merozoits at the periphery and dark malarial pigments at the center, gametocytes are round, all these stages are seen in peripheral Bl.P. falciparum
The parasites infect all ages of R.B.C. rings are small, multiple infection in one R.B.C.is common, ring may have double chromatin dots-2 N- Schizonts are rally seen at the peripheral Blood. Except in sever infection with high parasitemia, schizogony take place in the capillaries of muscles and viscera, mature schizont has 8-32 merozoit .gametocytes are cresent in shape, only ring and gametocytes are ordinarily seen in the peripheral Bl.
P. ovle
Commonly seen in west Africa. The infected R.B.C.is slightly enlarged and oval in shape and show schuffners dots, it has irregular or fimbriated appearace of the edges of the infected R.B.C. mature schiz. cotains 8 meroz. malarial pigments is coarse and brown.Life cycle
Genus Plasmodium requires 2 host complete their life cycle.Vertebrate (Human) host-asexual cycle-schizogony. (intermediate host)
Invertebrate (female Anopheles mosquito) host-sexual cycle-sporogony. (final host).
Life Cycle
Life Cycle
Life Cycle
Life Cycle
Relapses
Relapses in P.vivax is up to 3-4 years.Relapses in P.ovale is up to 4-5 years.
stages of different malaria species(erythrocytic cycle)
SSSS
P.falciparum ring,gametocyte&mature schizote.
Thick blood film showing susage shape gametocyte of P. falciparum.
Thin blood of P.vivax showing gametocyte notice enlarged RBC.the gamete is rounded with compact Nu.on one side.